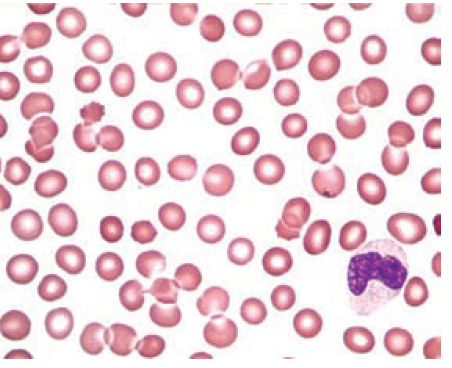
A 48-year-old woman was admitted to a hospital because of wheezing, cough, fatigue, and difficulty breathing. Her history included diabetes and hypertension. Her CBC data show a hemoglobin of 8.2 g/dL (82 g/L), RBC count of    and mCV = 109.8 fL. Her WBC count and platelet count were within the reference interval.  Consider the actions that the clinical laboratory professional should take.  Because of the abnormal values found in the CBC, the laboratory professional made a blood smear and performed a WBC differential and complete evaluation of the RBCs and platelets. The primary abnormal finding is seen in the following smear image.  The laboratory professional warmed the EDTA blood sample from this patient at 37 °C for 15 minutes and then reanalyzed the CBC on the analyzer and made a new smear. The new smear appeared as in the following figure. The new values were as follows: hemoglobin of 8.2 g/dL (82 g/L), RBC count of    and MCV of 91 fL.    Calculate the hematocrit, MCH, and MCHC on the warmed specimen. How have they changed?

Clinical Laboratory Hematology 3rd Edition by Shirlyn McKenzie, Lynne Williams
النسخة 3الرقم المعياري الدولي: 978-0133076011
Clinical Laboratory Hematology 3rd Edition by Shirlyn McKenzie, Lynne Williams
النسخة 3الرقم المعياري الدولي: 978-0133076011 تمرين 2
A 48-year-old woman was admitted to a hospital because of wheezing, cough, fatigue, and difficulty breathing. Her history included diabetes and hypertension. Her CBC data show a hemoglobin of 8.2 g/dL (82 g/L), RBC count of 
and mCV = 109.8 fL. Her WBC count and platelet count were within the reference interval.
Consider the actions that the clinical laboratory professional should take.
Because of the abnormal values found in the CBC, the laboratory professional made a blood smear and performed a WBC differential and complete evaluation of the RBCs and platelets. The primary abnormal finding is seen in the following smear image.
The laboratory professional warmed the EDTA blood sample from this patient at 37 °C for 15 minutes and then reanalyzed the CBC on the analyzer and made a new smear. The new smear appeared as in the following figure. The new values were as follows: hemoglobin of 8.2 g/dL (82 g/L), RBC count of
and MCV of 91 fL.
Calculate the hematocrit, MCH, and MCHC on the warmed specimen. How have they changed?

and mCV = 109.8 fL. Her WBC count and platelet count were within the reference interval.
Consider the actions that the clinical laboratory professional should take.
Because of the abnormal values found in the CBC, the laboratory professional made a blood smear and performed a WBC differential and complete evaluation of the RBCs and platelets. The primary abnormal finding is seen in the following smear image.
The laboratory professional warmed the EDTA blood sample from this patient at 37 °C for 15 minutes and then reanalyzed the CBC on the analyzer and made a new smear. The new smear appeared as in the following figure. The new values were as follows: hemoglobin of 8.2 g/dL (82 g/L), RBC count of

and MCV of 91 fL.
Calculate the hematocrit, MCH, and MCHC on the warmed specimen. How have they changed?
التوضيح
In the given case study, the values of H...
Clinical Laboratory Hematology 3rd Edition by Shirlyn McKenzie, Lynne Williams
لماذا لم يعجبك هذا التمرين؟
أخرى 8 أحرف كحد أدنى و 255 حرفاً كحد أقصى
حرف 255








